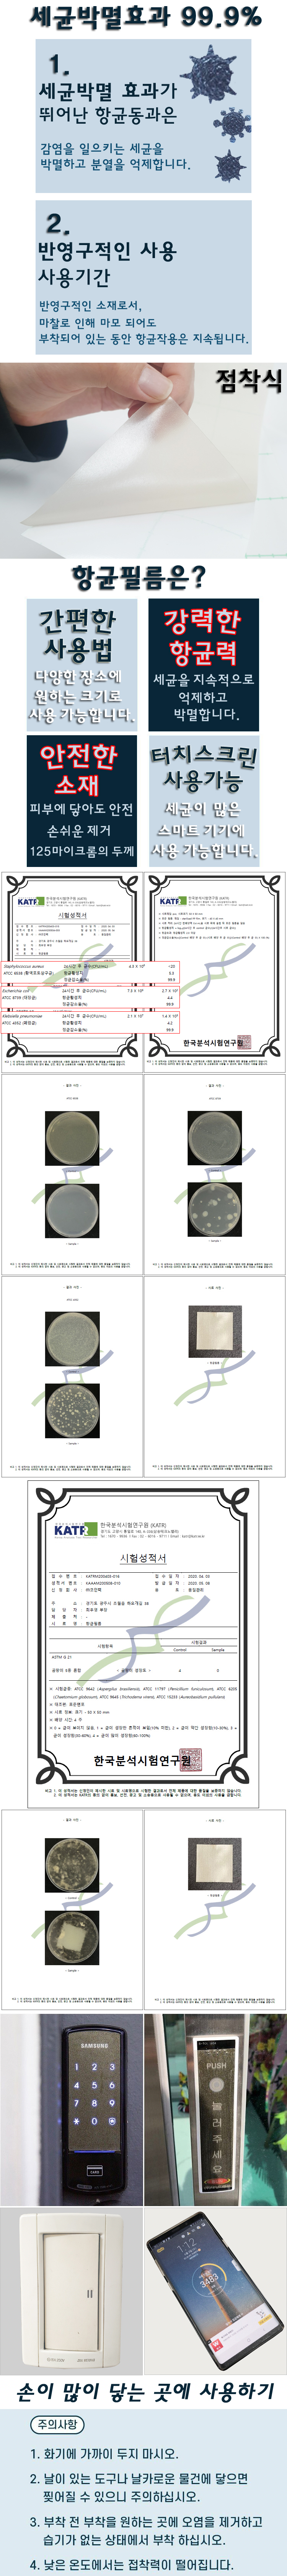
3a059d0a6a51abe40b475dadbb46a8b9_1591183546_1446_1335108201.jpg

|
|
 |
|
 |
|
|
상품 정보상품 상세설명
- 규격 : 가로 폭122cm(고정) x 길이50cm (구매 수량만큼 연결해서 재단합니다.최대30m) 사용후기등록된 사용후기사용후기가 없습니다. 상품문의등록된 상품문의상품문의가 없습니다. 배송정보오후 2시 이전 주문완료건(제작건 제외)에 대해서는 당일발송을 원칙으로 합니다. 단,재고부족 상품은 입고후 출고되며 최대 4~5일 더 소요됩니다.
제품 상세설명에 명시된 배송제한 상품은 배송책임을 지지 않습니다.
공장직배송 상품 및 주문상품은 당일 발송이 되지 않습니다.
배송 방법 : 택배
단 수도권지역 대량주문건에 대해서는 퀵(화물차)으로 배송해드립니다. 배송 지역 : 전국지역 배송 비용 : 개별배송 상품을 제외하고 70,000원 미만 구매시 배송비 4,000원이 추가됩니다(배송비가 인상되었습니다) 배송 기간 : 2일 ~ 7일 배송 안내 - 산간벽지나 도서지방은 별도의 추가금액을 지불하셔야합니다. 고객님께서 주문하신 상품은 입금 확인후 배송해 드립니다. 다만, 상품종류에 따라서 상품의 배송이 다소 지연될 수 있습니다 교환/반품교환 및 반품이 가능한 경우 - 상품을 공급 받으신 날로부터 3일이내 게시판이나 전화로 별도 연락을 주셔야하고, 7일이내 교환/반품할 제품을 보냅니다. 포장을 개봉하였거나 포장이 훼손되어 상품가치가 상실된 경우에는 교환/반품이 불가능 하오니 반드시 전화문의 바랍니다.
- 공급받으신 상품 및 용역의 내용이 표시.광고 내용과 다르거나 다르게 이행된 경우에는 공급받은 날로부터 15일이내 교환 및 반품이 불가능한 경우 - 고객님의 책임 있는 사유로 상품등이 멸실 또는 훼손된 경우. 단, 상품의 내용을 확인하기 위하여 포장 등을 훼손한 경우는 제외 - 포장을 개봉하였거나 포장이 훼손되어 상품가치가 상실된 경우 - 고객님의 사용 또는 일부 소비에 의하여 상품의 가치가 현저히 감소한 경우 - 시간의 경과에 의하여 재판매가 곤란할 정도로 상품등의 가치가 현저히 감소한 경우 - 제작상품의 경우 교환이나 반품이 불가. - 복제가 가능한 상품등의 포장을 훼손한 경우 - 모든 펜이나 잉크류는 물품의 하자 즉,기능상의 문제가 없을시엔 반품이나 환불 혹은 교환조치가 될 수 없음을 알려드립니다. - 필기류나 잉크류는 제품의 개봉시 사용함으로 간주되어 새상품으로 재판매가 이루어 질 수 없는 상품 입니다. (기능상의 문제라 함은 외관상이나 펜의 가장 중요한 기능 즉,필기시엔 전혀 문제의 여지가 없다거나 소비자의 부주의로 인한 긁힘현상,떨어뜨림 등으로의 문제로는 배상조치 할 수 없습니다.) (자세한 내용은 고객만족센터 1:1 E-MAIL상담을 이용해 주시기 바랍니다.) ※ 고객님의 마음이 바뀌어 교환, 반품을 하실 경우 상품반송 및 재출고 비용은 고객님께서 부담하셔야 합니다.(색상 교환, 사이즈 교환 등 포함) |
|
|
 |
사업장 소재지. 경기도 부천시 부천로24번길 3 / 상호. 학생화방문구센터 / E-mail. haksaeng4200@naver.com 고객센터. 032-654-4200 / 팩스. 032-654-4208 / 사업장등록번호. 130-08-74852 사업자 정보 확인 대표. 김혜란 / 개인정보관리책임자. 김혜란 / 통신판매업신고번호. 제2005-457호 |
 |
| copyright 2011 (c) haksaeng co., ltd all rights reserved. | contacts webmaster for more information 본 사이트는 게시된 이메일 주소나 기타 정보가 수집 프로그램이나 그 밖의 기술적인 장치를 이용하여 무단으로 수집되는 것을 거부하며, 이를 위반 시 정보통신망법에 의해 형사처벌됨을 유념하시기 바랍니다. |